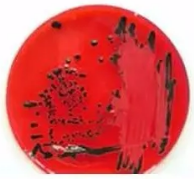
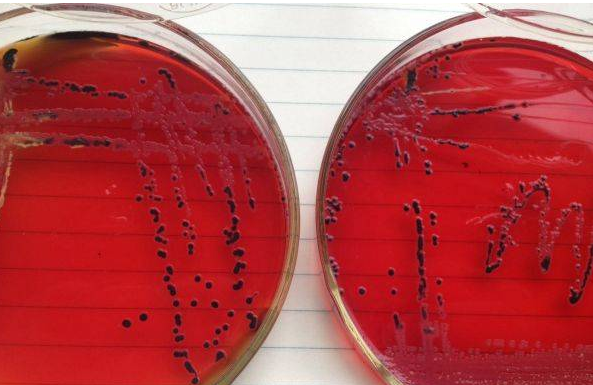

【收藏】沙门氏菌检测过程

预增菌

样品加入缓冲蛋白胨水(BPW)中进行预增菌,任何样品均需进行预增菌。有盆友问啦,为什么要用BPW呢?那是因为啊,食品在加工过程中采用加热、干燥等加工工艺使得细胞存在不同程度的受损,而缓冲蛋白胨水(BPW)呢,作为非选择性的增菌培养基,较高pH的缓冲体系可以帮助受损的细胞恢复到稳定、活力满满的生理状态,此处也可使用即用型的BPW,因为它操作方便,节省时间。
增菌接种前一定要把预增菌后的BPW样品溶液轻轻摇动混匀,这样做的原因是有些沙门君是懒得动的(因为有些沙门氏菌没鞭毛),它们会潜伏在溶液底层,所以我们要把增菌液“摇摆、摇摆”,让不动的沙门君们在增菌液中都漂浮起来,吸出,分别接入TTB和RVS培养基中。
此步骤防止漏检的方式是采用两种不同的选择性增菌液(TTB和RVS)进行增菌,是因为沙门君的家族太庞大了,血清型都有2000多种,所以得加强引诱措施,采用不同的培养温度和不同抑制性的培养基来给不同的沙门君提供安逸的环境来繁衍后代,同时尽量阻拦革兰氏阳性菌和其他大多数的肠道菌来捣乱,有些细菌还是会趁虚而入的。
将乳粉轻轻缓慢倾倒在BPW的液面。
勿混匀勿调节pH,室温静置60 min±5min。
静置完后再混匀,培养。
BPW勿预温。
咱们来说一下TTB和RVS使用过程中的注意事项:
TTB培养基:
待基础培养基冷却至50℃以下时,加入煌绿和碘液,因为培养基中含有不溶解的CaCO3(用来中和吸收有毒性的代谢物质),会有大量的白色沉淀,在分装时应边摇匀边分装。
操作注意事项:
1.将BPW接种到TTB后,一定要混匀。
2.TTB基础煮沸杀菌,不能高压灭菌,使用当天再加碘液和煌绿。
3.绝大部分预包装食品是低背景菌,生禽肉等初级农产品属于高背景菌样品。
4.背景菌不明的样本,如PT样品, 36 ℃±1 ℃和42 ℃±1 ℃两个温度同时培养。
RVS培养基:
需要高压灭菌,这里用RVS代替SC,BPW的接种量改为0.1mL,接种后培养条件为:42℃±1℃培养18h-24h;

分离

TTB与RVS增菌液在接种选择性分离培养基前,均应轻轻摇动混匀,原因同选择性增菌一样,也是为了防止不运动的沙门氏菌漏检;混匀后,用直径为3mm的接种环(也就是实验室用的10μL接种环)将TTB与RVS增菌液“分别”划线接种于两种选择性平板,一种是BS琼脂,为必选的选择性分离培养基,另外一种选择性分离培养基是从XLD琼脂、HE琼脂、沙门显色培养基中选择一个即可;沙门氏菌属在不同选择性琼脂平板上的菌落特征参考下图:

注意:在一种选择性琼脂培养基上不同沙门氏菌会长出不同的菌落形态,在做样品检验时要参考上图中沙门氏菌的菌落特征,将典型菌落及可疑菌落纯化后做生化和血清鉴定,避免漏检,例如:在XLD琼脂接菌培养18h-24h时,鼠伤寒沙门氏菌为粉红色菌落,呈现大的带光泽的黑色中心,大肠埃希氏菌为黄色菌落,猪霍乱沙门氏菌为淡黄色菌落,比大肠埃希氏菌的颜色略浅,易混淆,为防止漏检,XLD琼脂平板上黄色菌落也应做生化和血清鉴定,不可忽视。
咱们来说一下选择性琼脂培养基使用过程中的注意事项:
BS琼脂:配制时不可高压,煮沸灭菌即可,不可反复溶解,避免降低其选择性;特别需要注意的一点是必须使用前一天配制,且在48h内使用,超过48h也会降低其选择性,请于室温暗处贮存,接种后培养条件为:36℃±1℃培养40h-48h;

XLD琼脂:配制时不可高压,煮沸灭菌即可,不可反复溶解,避免降低其选择性,请于室温暗处贮存;该培养基宜于当天配置,第二天使用,接种后培养条件为:36℃±1℃培养18h-24h;
HE琼脂:配制时不可高压,煮沸灭菌即可,不可反复溶解,避免降低其选择性;接种后培养条件为:36℃±1℃培养18h-24h;

生化实验

沙门氏菌的生化和血清学鉴定试验的操作较繁琐,也有较多的操作点需要注意,否则检测结果容易出错。
1.三糖铁琼脂和赖氨酸脱羧酶试验
根据GB4789.4-2024的表1中沙门氏菌属的典型菌落特征描述,从选择性琼脂平板上分别挑取4个以上典型或可疑菌落(用接种针自菌落中心挑取),直接接种于三糖铁琼脂和赖氨酸脱羧酶试验培养基,同时用接种环挑取相同菌落划线营养琼脂平板及其他合适的非选择性固体培养基平板进行纯化,36℃±1℃培养16h-24h,必要时可延长培养至48h。
1.1三糖铁试验
注意 三糖铁琼脂接种时先在斜面划线,再于底层穿刺,但高层穿刺时接种针不能穿到底部,接种太深,否则有些菌产生的硫化氢会布满试管底部,影响底层培养基颜色变化的观察。

建议接种后的三糖铁琼脂安瓿瓶用封口膜轻轻的覆盖在瓶口,防止培养过程中培养基失水干缩后氧气进入,底部的黄色被氧化变色,影响结果观察;再用接种针在封口膜上扎些小孔利于培养过程中氧气的供应。
1.2赖氨酸脱羧酶试验
原理:某些细菌在酸性厌氧环境,且有赖氨酸底物存在的情况下能诱导产生赖氨酸脱羧酶,使赖氨酸脱羧产生碱性物质尸胺,导致培养基变紫,但不产生赖氨酸脱羧酶的细菌只能代谢葡萄糖产酸培养基变黄。
注意 在进行赖氨酸脱羧酶试验时,注意要挑取同一个待检菌落同时接种氨基酸脱羧酶对照管和赖氨酸脱羧酶试验管各一支,接种后在对照管和试验管液面上方均需加无菌液体石蜡(一定要是无菌的)覆盖。
您是否疑问为什么非要加无菌的液体石蜡?
由于氨基酸脱羧的产物尸胺、腐胺等遇氧不稳定,所以需要加无菌液体石蜡覆盖隔绝空气,保持胺的稳定性,确保试验结果的真实性。
1.3生化结果初步判断
根据三糖铁琼脂和赖氨酸脱羧酶试验结果,参考GB4789.4-2024中表2来初步判断是否有可疑的沙门氏菌。

根据表2的描述,如果遇到①三糖铁琼脂的试验管底部变红;②整个三糖铁琼脂试管为黄色,并且赖氨酸脱羧酶试验为阴性的试验结果时,说明该菌株为非沙门氏菌,不需再做后续的生化试验。
2.靛基质、尿素酶和氰化钾生长试验
如果初步判断符合可疑沙门氏菌属的生化结果时,挑取纯化好的可疑菌落,再继续做靛基质、尿素酶和氰化钾生长试验,这三步试验也可与三糖铁琼脂、赖氨酸脱羧酶试验同时做,36℃±1℃培养16h-24h,必要时可延长培养至48h,纯化后的营养琼脂平板储存于2℃-5℃或室温至少保留24h,以便进行后续的生化试验和必要时复查。
2.1靛基质试验
将纯化后的可疑菌株接种至蛋白胨水中,36℃±1℃培养18h-24h,培养后沿管壁缓慢的加入柯凡克试剂或欧-波试剂,若此可疑菌株可分解蛋白胨中的色氨酸生成吲哚,吲哚与靛基质试剂中的对二甲氨基苯甲醛反应生成红色的玫瑰吲哚,为阳性;若不分解色氨酸则仍是黄色,为阴性。

2.2尿素酶试验
某些细菌产生的尿素酶分解尿素可产生大量的碱性物质-氨,使培养基pH值升高,指示剂酚红变成红色,为阳性;
在试验操作时,应待灭菌后的尿素琼脂基础冷却至55℃时,再每95mL基础中加入5mL 40%尿素水,防止基础温度过高使尿素水分解,充分混匀后分装试管,制成斜面。

2.3氰化钾试验
该试验的目的是为了鉴别细菌能否被一定浓度的氰化钾抑制而导致细菌不生长;若试验管生长浑浊为阳性,不生长且澄清的为阴性。
注意 在进行试验操作时,应将同一株可疑菌同时接种氰化钾对照管和试验管各一支;
氰化钾试验操作时易失败的主要原因:
在氰化钾对照管和试验管接种可疑菌株后,应使用无菌的液体石蜡覆盖液面,若不覆盖,氰化钾会逐渐分解,产生氢氰酸气体逸出,以致氰化钾浓度降低,细菌生长,造成假阳性的结果。
氰化钾为剧毒物质,可抑制呼吸酶,造成细胞内窒息,吸入、口服或经皮肤吸收均可引起急性中毒,在操作该试验时应做好个人防护,避免接触、入口或吸入。
废弃处理 试验结果观察结束后,在每管中加入0.5mL的40%氢氧化钾溶液和数粒硫酸亚铁,反应数小时后,建议121℃高压灭菌30min,废弃。
根据以上的试验结果,查询表3对沙门氏菌属进行初步鉴定:
反应序号A1:

当试验结果符合A1时,为沙门氏菌属的典型反应,生化结果可初步判定为沙门氏菌;
若此表格中,有1项不符合时,再参考表4中的“判定结果”再进行血清或生化的验证试验;
若有2项结果不符合时,判定为非沙门氏菌。
表4判定结果解读:

若试验结果为第1种情况时,生化结果初步鉴定为甲型副伤寒沙门氏菌,需通过查询WKLM抗原表,确定甲型副伤寒沙门氏菌的O抗原和H抗原的因子,再进行血清学的验证试验。
若试验结果为第2种情况时,生化结果初步鉴定为沙门氏菌IV或V,若需分清是IV还是V,就需要按照表5做相应的生化试验再进行分群,最终的鉴定还需要参考血清学鉴定的结果共同确定。

若试验结果为第3种情况时,生化结果初步鉴定为沙门氏菌个别变体,需要再做血清学鉴定试验。
反应序号A2:
当试验结果符合A2时,需要再做甘露醇和山梨醇两项试验,若补做的甘露醇和山梨醇均为阳性结果时,继续做血清学鉴定试验,结合血清学的试验结果进行判定;
反应序号A3:
当试验结果符合A3时,需补做ONPG试验;
若赖氨酸脱羧酶为阳性,ONPG为阴性时生化结果初步判定为沙门氏菌;
若赖氨酸脱羧酶和ONPG的结果均为阴性时,生化结果初步判定为甲型副伤寒沙门氏菌。

血清学鉴定

血清学鉴定试验是必做的项目,血清学分型为选做项目可根据各自实验室的需求选择。
实验室应配备沙门氏菌多价菌体(O)和多价鞭毛(H)诊断血清。
1. 沙门氏菌属的抗原结构简介
O抗原:也称为菌体抗原,是细胞壁的组成成分,O抗原与抗血清的反应呈颗粒状;
H抗原:也称为鞭毛抗原,不同细菌的H抗原具有特异性,常作为血清学鉴定的依据之一;H抗原与抗血清的反应呈絮状或绒状,大部分沙门氏菌H抗原都有两相,第一相被称为特异性相,第二相为非特异性相;
Vi抗原:是一种特殊的菌体抗原,属于K抗原群,如伤寒沙门氏菌、丙型副伤寒沙门氏菌和都柏林沙门氏菌都含有Vi抗原。
2. 培养物自凝性的检查
在一块洁净的玻片上滴加一滴生理盐水,挑取琼脂量为1.2%-1.5%的培养基平板上纯化的菌株,混合于生理盐水滴中,混匀,成为均一性的混浊悬液,将玻片轻轻混动30s-60s,置于黑色背景下观察凝集情况,若出现可见的菌体凝集,则认为有自凝性,说明该菌株发生S-R变异,失去了O抗原成为粗糙型,不能进行血清学鉴定试验;反之无自凝性,若无自凝性则继续做后续的血清学试验。
注意 在做血清学鉴定试验中,菌株建议使用纯化培养18-24h的新鲜菌株;
菌株纯化时,建议使用营养琼脂培养基,尽量不用平板计数琼脂,是因为平板计数琼脂配方中含有糖类,糖类会干扰血清学的鉴定;营养琼脂培养基的琼脂量在1.2%-1.5%之间。
3. O多价菌体抗原的鉴定
在洁净的玻片的一边滴加一滴生理盐水作为对照,另一边滴加一滴O多价血清;
自营养琼脂平板挑取1环纯化后的待测菌,在生理盐水滴和多价菌体(O)抗血清滴上方各放1/2环待测菌,再用无菌的接种环分别将两个区域内的菌苔研磨成乳液状,将玻片轻轻混动1min,置于黑色背景下观察,任何程度的凝集现象皆为阳性反应。
注意 研磨菌株时应先研磨生理盐水区域,再研磨O多价血清区域;若先研磨O多价血清区域,再研磨生理盐水区域,有可能会把O多价血清带入到生理盐水区域,造成误判。
若O多价不凝集时就判定为非沙门氏菌吗?
此时需要考虑是否因为荚膜的原因而导致的O多价不凝集,分为以下两步进行排除:
I. 将菌株接种在琼脂量较高(2%-3%)的培养基上,培养后,再进行O多价凝集试验,这里说的高琼脂量的培养基,可以在实验室中,按每100mL营养琼脂培养基(脱水干粉培养基)中加入1g的琼脂,再高压灭菌,倒平板备用。
在较高琼脂量的培养基上再纯化的原因:因为菌株在琼脂量较高的培养基上荚膜发育不良,可以暴漏出O抗原,有利于检测是否有菌体抗原存在;
II. 若是因为有Vi抗原存在而阻止O凝集反应时,可多挑取纯化后的待测菌株置于1mL生理盐水中制成浓菌液,在沸水中水浴20 min~30 min,破坏荚膜的多糖和抗原,暴露O抗原,需要待菌液冷却后再进行O多价血清的鉴定。
4. H多价鞭毛抗原的鉴定
操作与O多价鉴定步骤相同;
但H抗原发育不良时,H多价血清也会不凝集,此时需要将菌株接种琼脂量更低(0.55%-0.65%)的半固体琼脂平板中央,培养后,菌株蔓延生长至平板的边缘时,取最边缘的菌株进行H多价血清凝集试验;
注意 若培养后菌株未蔓延生长,则需要再次转种半固体琼脂培养基,直至蔓延生长;
为什么H多价血清鉴定需要琼脂量更低的半固体琼脂平板?
因为H多价血清的鉴定需要菌株的鞭毛发育良好,而培养基的琼脂量更低时,含有的水分就越多,越有利于菌株鞭毛的发育和爬行。
促进鞭毛发育的另一种方法是将菌株通过接种装有0.3%-0.4%半固体琼脂的小玻管1-2次,自远端取菌培养后再检查,该方法操作较复杂。

结果与报告

综合以上生化试验和血清学鉴定的结果,报告25g(mL)样品中检出或未检出沙门氏菌。
食品微生物检测
展源
何发
热点文章
-
硫酸稀释是酸入水还是水入酸?
2026-04-23
-
【必看】实验滴定终点变色顺口溜
2026-03-24
-
【必看】红外光谱仪结构图与原理
2026-04-28
-
【收藏】标准溶液的配制和计算
2026-04-07
-
【必看】灭菌F₀值及其计算方法
2026-03-13
-
提效增能·创新提质 色谱质谱助力食品安全技术能力建设
2026-03-24
-
HJ 166-2026 土壤环境监测技术规范
2026-03-03
-
独立百天,新生启航:Solstice Advanced Materials中国首秀,锚定先进计算、可持续发展、生命科学新航道
2026年1月末,距离从霍尼韦尔正式分拆独立,并在纳斯达克挂牌上市将满百日时,全新的特种材料公司 Solstice Advanced Materials在上海举办了其独立运营后的首次中国媒体见面会。
作者:张明
-
安捷伦在中国:加速本土创新与绿色发展的双重推进
-
洞察未来,共谋发展 “ 数·智·未来 ” 安捷伦未来实验室媒体圆桌会成功举办
-
食品检验理化常用国家标准与要点
-
水分测定方法开发研究&检测相关问题故障分析解决解读
-
药物常用的晶型表征方法









评论
加载更多